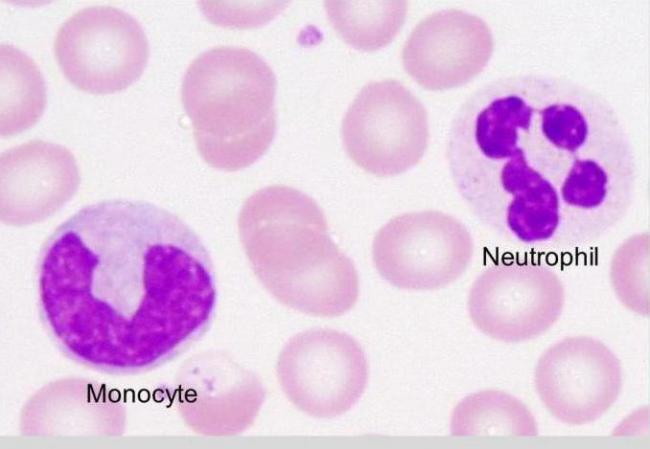
1540389.jpg

О чем говорит повышение незрелых гранулоцитов в анализе крови?
Этиология повышения незрелых гранулоцитов в крови
Повышенные показатели незрелых гранулоцитов указывают на то, что в организме развиваются патологические процессы. Организм продуцирует нейтрофилы в большом количестве, чтобы защитить себя от инфекции. Причины появления незрелых гранулоцитов могут носить и физиологический характер.
Так юные гранулоциты повышены:
У новорожденных малышей,
- У беременных женщин,
- У людей в стрессовых ситуациях,
- После приема пищи,
- У женщин в период месячных,
- Во время и некоторое время после тяжелой физической нагрузки.
Показатели незрелых гранулоцитов повышены что это значит?
Это означает, что у пациента могут быть:
- Отравления или какие-либо интоксикации (свинцом),
- Сердечно-сосудистые проблемы (инфаркт миокарда),
- Ожоги (термические, химические),
- Злокачественные образования,
- Реакции на проведенную вакцинацию,
- Нетипичные реакции на прием некоторых лекарственных средств,
- Потери крови,
- Хронические патологии кожных покровов (дерматиты, псориаз),
- Симптомы сывороточной болезни,
- Инфаркты легкого,
- Гангренозные процессы,
- Гнойные явления (абсцессы, флегмоны),
- Пневмонии,
- Воспалительные процессы (ангина, менингит, холецистит, аппендицит, перитонит, пиелонефрит, остеомиелит),
- Инфекционные заболевания (гепатит, брюшной тиф, туберкулез, корь, краснуха, грипп).
Гранулоцитарные лейкоциты
Резкий сдвиг лейкоцитарной формулы определяется при миеломоноцитарном лейкозе, а также при гнойных процессах. Изменяется не только количество гранулоцитов, но и «качество» их клеток.
У ребенка незрелые гранулоциты в крови увеличиваются при:
- Ожогах 3 и 4 степени тяжести,
- Трофических язвах,
- Лейкозе,
- Ацидозе,
- Остром инфекционном заражении (отите, пневмонии),
- Гемолитической анемии.
Что такое лейкоциты?
Основные гранулоциты — это нейтрофилы, иначе именуемые лейкоцитами. Их задача заключается в избавлении организма от следующих видов патогенных микроорганизмов: вирусов, бактерий, паразитов. Повышение их числа свидетельствует о борьбе с инфекциями и о том, что пациенту следует провериться на перечисленные виды заражения.
Инфекция может быть и внутренней, поэтому без врача найти источник недомогания будет сложно, и при отсутствии медицинского образования можно запутаться в терминах и определениях. Лейкоциты угнетаются и погибают под действием сильнодействующих лекарственных средств. Это следует помнить и перед сдачей анализов нужно сделать перерыв в приёме препаратов.
Также количество лейкоцитов снижается при состояниях, когда человек имеет заболевания крови. Задачей белых клеток становится уничтожение болезнетворных частиц методом поглощения. Вследствие этого защитные тельца погибают. До образования у них такой способности проходит процесс созревания.
Вырабатываются лейкоциты (нейтрофилы) в костном мозге. Часть из них всегда находится в пристеночном пространстве сосудов, остальные постоянно блуждают по организму. Время их жизни около 7 дней в кровяной жидкости. В тканях срок существования сокращается и составляет не более 2-х дней.
Виды гранулоцитов
Гранулоциты делят на нейтрофильные, базофильные и эозинофильные в зависимости от того, как они воспринимают стандартные красители. Размер этих клеток составляет 9-12 мкм.
Нейтрофилы – самая многочисленная группа зернистых лейкоцитов. Их название связано с тем, что по методу Романовского они окрашиваются как основным красителем, так и кислым (эозином). Зрелые нейтрофильные гранулоциты являются полиморфноядерными клетками, поскольку их ядро состоит из четырех-пяти сегментов. В крови у здорового человека циркулируют в основном зрелые сегментоядерные формы и небольшое количество палочкоядерных гранулоцитов.
Эозинофилы получили свое название в связи с тем, что окрашиваются только кислым красителем (эозином) и не поглощают основной. Их ядро состоит из двух долей.
Частые вопросы
Какие причины могут привести к повышению незрелых гранулоцитов в анализе крови?
Повышение незрелых гранулоцитов в анализе крови может быть вызвано инфекционными заболеваниями, воспалительными процессами, стрессом, травмами, а также приемом определенных лекарственных препаратов.
Какие симптомы могут сопровождать повышение незрелых гранулоцитов в крови?
Симптомы, сопровождающие повышение незрелых гранулоцитов, могут включать усталость, слабость, повышенную температуру, боли в области живота или костей, а также учащенное сердцебиение.
Полезные советы
СОВЕТ №1
Обратитесь к врачу для более детального анализа результатов и получения профессиональной консультации.
СОВЕТ №2
Избегайте самолечения и не паникуйте, так как повышение незрелых гранулоцитов может быть связано с различными факторами, включая инфекции, стресс, или даже физическую нагрузку.
 У новорожденных малышей,
У новорожденных малышей,
О чем говорят незрелые гранулоциты в анализе крови
О чем говорят незрелые гранулоциты в анализе крови
 Если незрелые гранулоциты повышены — что это может значить?
Если незрелые гранулоциты повышены — что это может значить?


 Гранулоциты - это что такое?
Гранулоциты - это что такое? Почему нейтрофилы повышены у взрослого
Почему нейтрофилы повышены у взрослого Сегментоядерные нейтрофилы в анализе крови - причины и последствия отклонений от нормы у детей или взрослых
Сегментоядерные нейтрофилы в анализе крови - причины и последствия отклонений от нормы у детей или взрослых О чём говорит высокий уровень нейтрофилов и опасно ли это?
О чём говорит высокий уровень нейтрофилов и опасно ли это?